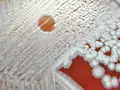

فاژ
باکتریوفاژها (باکتریخوارها) یا به اختصار فاژها، ویروسهایی هستند که به باکتریها حمله میکنند و آنها را از بین میبرند. این ویروسها برای باکتریها اختصاصی هستند و نمیتوانند به یوکاریوتها حمله کنند.[1]

تاریخچه

در سالهای ۱۹۱۵و ۱۹۱۷ دو دانشمند به نامهای فردریک تاوورت (به انگلیسی: Frederick Twort) و فلیکس دهرله (به انگلیسی: Félix d'Hérelle) در ضمن آزمایشهای خود بهطور اتفاقی به وجود این فاژها پی بردند. این دو دانشمند با رشد باکتریهای مختلف در محیطهای کشت مایع متوجه از بین رفتن خود به خود این باکتریها شدند. این دانشمندان پس از مطالعات خود و با صاف نمودن این محیطهای حاوی فاژ توسط فیلترهای باکتری شناسی، وجود باکتریوفاژها را اثبات کردند.
تعریف
باکتریوفاژها ویروسهایی هستند که باکتریها را آلوده میکنند. انواع بسیار مختلفی از باکتریوفاژها وجود دارند که به گونههای خاصی از باکتریها تمایل دارند و فقط میزبان باکتریایی خاصی را آلوده میکنند. فاژها مانند سایر ویروسها دارای یک اسید نوکلئیک درونی (DNA یا RNA) هستند که این ژنوم توسط یک پوشش پروتئینی حفاظتی در خارج احاطه شدهاست.[1]
تقسیم بندی باکتریوفاژها
مبنای طبقهبندی باکتریوفاژها نوع اسید نوکلئیک آنها (DNA یا RNA) و بعد از آن، شکل و ساختار آنها میباشد. آنها بر اساس ساختار به سه شکل بیست وجهی (به لاتین: Icosahydral) مانند MS2، رشتهای (به انگلیسی: Filamentus) یا مارپیچی(به انگلیسی: Helical) مانند M13 و فاژهای دارای سر و دم (به انگلیسی: Head and tail) مانند فاژهای فاژهای T4و λ طبقهبندی میشوند.
فاژهای دم دار دارای دو رشته DNA یعنی کادوویرالها (به لاتین: Caudovirales)، بیش از ۹۵% فاژهای موجود در متون علمی را به خود اختصاص دادهاند و به نظر میرسد فراوانترین نوع فاژ بر روی کره زمین باشند. فاژها توسط کمیته بینالمللی تاکسونومی ویروسها (به انگلیسی: International Committee on Taxonomy of Viruses) طبقهبندی میشوند.[1] تاکنون ۱۹ خانواده از فاژها شناخته شدهاند که فقط ۲ خانواده دارای ژنوم RNA و ۵ خانواده دارای انولوپ (پوشش پروتئینی) هستند. در فاژهای دارای ژنوم DNA، فقط ۲ خانواده دارای ژنوم تک رشتهای، ۸ خانواده دارای ژنوم حلقوی و ۹ خانواده دارای ژنوم خطی میباشند. ۹ خانواده فقط باکتریها را آلوده میسازند. ۹ خانواده آرکئا (آرکی باکترها) را آلوده میکنند و یک خانواده یعنی تکتی ویریده (به لاتین: Tectiviridae)هم باکتریها و هم آرکئا (آرکی باکترها) را آلوده میسازد. مهمترین خانوادههای فاژها عبارتند از[1]:
- میوویریده (به لاتین: Myoviridae): در راسته کادوویرالها قرار گرفتهاند. فاقد انولوپ (پوشش پروتئینی) بوده و دم منقبض شونده دارند. آنها دارای DNA دو رشتهای خطی هستند مانند فاژ T4.
- سیفوویریده (به لاتین: Siphoviridae): در راسته کادوویرالها قرار گرفتهاند. فاقد انولوپ (پوشش پروتئینی) بوده و دم غیر منقبض شونده طویل دارند. آنها دارای DNA دو رشتهای خطی هستند مانند فاژ λ و فاژ T5.
- پودوویریده (به لاتین: Podoviridae): در راسته کادوویرالها قرار گرفتهاند. فاقد انولوپ (پوشش پروتئینی) بوده و دم غیر منقبض شونده کوتاه دارند. آنها دارای DNA دو رشتهای خطی هستند مانند فاژ T7.
- لیپوتریکس ویریده (به لاتین: Lipothrixviridae): در راسته لیگامن ویرالها (به لاتین: Ligamenvirales) قرار دارند. آنها طویل بوده، دارای انولوپ هستند و DNA دو رشتهای خطی دارند.
- رودی ویریده (به لاتین: Rudiviridae): در راسته لیگامن ویرالها (به لاتین: Ligamenvirales) قرار دارند. آنها طویل بوده، فاقد انولوپ هستند و DNA دو رشتهای خطی دارند.
- آمپولاویریده (به لاتین: Ampullaviridae): بطری شکل، دارای انولوپ و DNA دو رشتهای خطی دارند.
- بی کاداویریده (به لاتین: Bicaudaviridae): لیمویی شکل، فاقد انولوپ و DNA دو رشتهای حلقوی دارند.
- کلاواویریده (به لاتین: Clavaviridae): طویل، فاقد انولوپ و DNA دو رشتهای حلقوی دارند.
- کورتیکوویریده (به لاتین: Corticoviridae): متقارن، فاقد انولوپ و DNA دو رشتهای حلقوی دارند.
- سیستوویریده (به لاتین: Cystoviridae): کروی، دارای انولوپ و RNA دو رشتهای چند قطعهای دارند.
- فوسلوویریده (به لاتین: Fuselloviridae): لیمویی شکل، فاقد پوشش و DNA دو رشتهای حلقوی دارند.
- گلوبولوویریده (به لاتین: Globuloviridae): متقارن، دارای انولوپ و DNA دو رشتهای خطی دارند.
- گوتاویروس (به لاتین: Guttavirus): بیضوی، فاقد انولوپ و DNA دو رشتهای حلقوی دارند.
- اینوویریده (به لاتین: Inoviridae): رشتهای (فیلامنتی)، فاقد پوشش و DNA تک رشتهای حلقوی دارند.
- لوی ویریده (به لاتین: Leviviridae): متقارن، فاقد پوشش و RNA تک رشتهای خطی دارند مانند فاژهای MS2 و Qβ.
- میکروویریده (به لاتین: Microviridae): متقارن، فاقد پوشش و DNA تک رشتهای حلقوی دارند مانند ΦX174.
- پلاسماویریده (به لاتین: Plasmaviridae): پلئومورف (چند شکلی)، دارای انولوپ و DNA دو رشتهای حلقوی دارند.
- تکتی ویریده (به لاتین: Tectiviridae): متقارن، فاقد انولوپ و DNA دو رشتهای خطی دارند.
فاژهای دارای DNA
- فاژهای دارای DNA تک رشتهای (ssDNA) بیست وجهی:
مطالعات بر روی این فاژها منجر به کشف همانند سازی به روش حلقه غلتان (به انگلیسی: rolling circle)و همچنین تعین هویت پروتئینهای دخیل در همانندسازی میزبان شد. از این گروه، فاژ ϕX۱۷۴ بیش از همه مورد مطالعه قرار گرفتهاست. ژنوم این فاژ، ssDNA حلقوی است که شامل ۵۳۸۶ نوکلئوتید است و ۱۱ ژن را کد میکند. این فاژ، اولین ژنوم دست نخوردهای بود که تعیین توالی شد. طول ژنوم کوتاهتر از ظرفیت کدگذاری است که آن نیز به علت هم پوشانی ژنی ایجاد شدهاست.
- فاژهای دارای DNA تک رشتهای (ssDNA) رشتهای:
از این گروه، فاژهای f1، fd و M13 بیش از همه مورد مطاله قرار گرفتهاند. این گروه از فاژها، سویههایی از E.coli را که دارای پیلی جنسی هستند را از طریق همان پیلی آلوده میکنند. اینها بر خلاف بسیاری از فاژهای دیگر، DNA خود را به میزبان تزریق نمیکنند بلکه به صورت کامل وارد میزبان میشوند و پوشش برداری داخل میزبان انجام میشود. به علاوه، این گروه میزبان خود را لیز نمیکنند بلکه ویریونهای حاصله بهطور مداوم در طول زندگی میزبان آزاد میشوند. با این حال، سرعت رشد این باکتریها نسبت به باکتریهای آلوده نشده کمتر میشود.
- فاژهای دارای DNA دو رشتهای:
این گروه از فاژها دارای تنوع زیادی میباشند. در این گروه، T7 و λ به خوبی مورد مطالعه قرار گرفتهاند. فاژ T4 در خانواده میوویریده «از myos به معنی عضله که به خاطر دم قابل انقباض این گروه میآید» قرار گرفتهاست. فاژهای T1 و T5 به همراه λ در خانواده سیفوویریده «از یونانی siphon به معنی لوله به خاطر دم غیر قابل انقباض» قرار دارند. فاژهای خانواده پودوویریده دارای دم غیر منقبض شونده کوتاه هستند مانند T7.
فاژ T4، یکی از بزرگترین فاژ هاست که شکل پیچیدهای دارد که شامل یک سر بیست وجهی پیچیده و یک دم قابل انقباض به همراه پایه، فیبرهای دمی و خارها میباشد. فیبرهای دمی، خارها و صفحه پایه در اتصال به لیپوپلی ساکارید باکتری میزبان به فاژ کمک میکنند. پس از اتصال، غلاف دمی منقبض میشود و به کمک آنزیم لیزوزیم «محصول ژن gp5 یا gene product ۵»، دیواره باکتری را هضم نموده و اسید نوکلئیک فاژ را به میزبان تزریق میکند. ژنوم فاژ دارای بازهای تغییر یافته ۵-هیدروکسی سیتوزین است که باعث حفاظت DNA فاژ در مقابل آنزیمهای محدودالاثر (به انگلیسی: restriction enzymes) میزبان میشود. ژنوم دارای ۳۰۰ ژن است که که توسط سه نوع راه انداز (به انگلیسی: promoter) تنظیم بیان میشود. ژنهای فوری (به انگلیسی: early)و میانی (به انگلیسی: middle) فعالیتهای لازم برای همانندسازی را کد میکنند و ژنهای تاخیری (به انگلیسی: late)، اجزای سر و دم و همچنین لیز سلول میزبان را کد میکنند.
فاژهای دارای RNA
- فاژهای دارای RNA تک رشتهای:
این گروه از فاژها، ویروسهای کوچک بیست وجهی هستند که دارای بیشترین میزان جهش ژنتیکی (موتاسیون) هستند و به عنوان کوچکترین ژنومهای RNA شناخته شدهاند. این فاژها، ویروسهای رشته مثبت (به انگلیسی: plus strand) هستند یعنی ژنوم آنها به عنوان mRNA عمل میکند و فقط شامل تعداد کمی ژن است. آنها باکتریهای گرم منفی مانند E.coli و سودوموناس را از طریق پیلی جنسی آلوده میکنند.
- فاژهای دارای RNA دو رشتهای:
باکتریوفاژ ϕ۶، اولین عضو این خانواده بود که جداسازی شد. این فاژ دارای ژنوم dsRNA قطعه قطعه شده میباشد که شامل سه قطعه با نامهای (L:large) حدود ۶۴۰۰ نوکلئوتید، (M:medium) حدود ۴۰۰۰ نوکلئوتید و (S:small) حدود ۳۰۰۰ نوکلئوتید میباشد. نسخه برداری (رونویسی)از ژنوم دو رشتهای برای سنتز رشتههای جدید توسط آنزیم RNApol وابسته به RNAی فاژ انجام میشود و رشته مکمل (اضافی یا Plus) به عنوان الگوی همانندسازی برای ساختن mRNA قرار میگیرد. ترجمه قطعه L، تولید پروتئینهای فاژ را سرعت میبخشد که در تشکیل کمپلکس پلیمراز نقش دارد. قطعه M، تولید پروتئینهای ساختاری برای غشاء و خارها را بر عهده دارد. قطعه S تولید پروتئینهای ساختاری برای کپسید، سر هم شدن غشاء و لیز شدن میزبان و یک پروتئین غیر ساختاری برای پوشش کپسید را بر عهده دارد.
چرخه زندگی فاژ

فاژها بر اساس چرخه زندگی به دو شکل لیتیک (به انگلیسی: lytic cycle)و لیزوژنی (به انگلیسی: lysogenic cycle)وجود دارند. در مثالهای زیر، این چرخهها توضیح داده شدهاند [2]:
- مسیر لیتیک فاژ T4:

فاژ T4 باعث آلودگی لیتیک E.coli میشود. ذرات فاژ به پروتئین گیرندهای به نام OMPc واقع در سطح باکتری متصل میشوند. سپس DNA فاژی از طریق ساختار دمی T4 به سلول تزریق میشود. در داخل سلول، رونویسی از داخل ژنهای فاژی آغاز شده و سنتز DNA، RNA و پروتئینهای سلول میزبان متوقف میشود DNAی باکتری، دپلیمریزه شده و این نوکلئوتیدها برای همانندسازی DNA فاژ مورد استفاده قرار میگیرند. پروتئینهای کپسید فاژ سنتز میشوند و ذرات جدید فاژی به تعداد زیادی افزایش مییابند. در نهایت، ۲۰۰ تا ۳۰۰ ذره فاژی جدید با تخریب میزبان آزاد میشوند.
- چرخه زندگی لیزوژنی (λ) لامبدا:
فاژهای معتدل (به انگلیسی: temperate phages) مثل لامبدا میتوانند E.coli را دچار آلودگی لیتیک کنند اما مسیر لیزوژنیک، بسیار معمول تر است. پس از اینکه فاژ، DNA خود را داخل سلول میزبان تزریق کرد، DNA حلقوی میشود. سپس با کروموزوم میزبان ادغام میشود. ادغام به وسیله نوترکیبی صورت میگیرد و شامل یک توالی فاژی دارای ۱۵ جفت باز همولوگ با توالی موجود در کروموزوم E.coli است. ادغام همیشه در یک جایگاه روی میدهد. به این شکل از ادغام، پروفاژ (به انگلیسی: Prophage) میگویند. پروفاژ تا چندین نسل آرام باقی میماند و همراه با کروموزوم میزبان، همانندسازی میکند. در نهایت، پس از تقسیمات متعدد سلولی، یک تحریک موجب روشن شدن سیکل آلودگی لیتیک میشود. این روشن شدن توسط برخی از محرکهای شیمیائی یا فیزیکی القاء میشود و شاید علامت نزدیک بودن مرگ باشد. در پاسخ به این محرکها، DNA فاژ با انجام یک نوترکیبی ملکولی از کروموزوم جدا میشود. ژنهای فاژ بیان شده و پروتئینهای فاژ سنتز میشود. DNA فاژ همانندسازی شده و در کپسیدها بسته بندی میشود. در نهایت، باکتری تخریب میشود ذرات فاژی جدید آزاد میشوند.
- بیان ژن در آلودگی لیتیک:
فاژها، درجات مختلفی از تنظیم بیان ژن را نشان میدهند. بهطور معمول همانندسازی ژنوم قبل از سنتز پروتئینهای کپسید انجام میشود. لیزوزیم (آنزیمی که باعث تخریب سلولی میشود) در انتهای چرخه لیتیک تولید میشود. در فاژهای ساده مثل ϕX۱۷۴، تنظیم بیان ژن به صورت حداقلی صورت میگیرد. تمام یازده ژن آن در زمان آلودگی به وسیله آنزیم RNA پلی مراز میزبان رونویسی میشود. با این حال، تولید لیزوزیم که در آخر مورد نیاز است با تأخیر صورت میگیرد چراکه ترجمه رونوشت آن بسیار کند تر از دیگر رونوشتها انجام میشود. در فاژهای ساده نیز مانند اغلب فاژهای دیگر دو مرحله بیان ژن معروف به زودرس (early) و دیررس (late) وجود دارد. بیان ژن زودرس بهطور معمول با همانندسازی ژنوم فاژ و بیان دیررس با تولید پروتئین ساختاری مرتبط است. ابتدا ژنهای زودرس رونویسی میشوند که خود مسئول فعالسازی بیان ژنهای دیررس هستند. در فاژ T4، ژنهای زودرس به وسیله RNA پلی مراز میزبان با استفاده از توالیهای راه انداز فاژ که در ژنهای طبیعی E.coli حضور دارند، رونویسی میشود. با رونویسی بعضی از این ژنها، پروتئینهایی کد میشوند که ویژگی RNA پلی مراز را تغییر میدهند تا راه اندازهای میزبان را نشناسد. این امر باعث میشود بیان ژن در میزبان خاموش شود. اما در عوض، منجر به رونویسی سری دوم ژنهای فاژ میشود. برخی از این ژنها پروتئینهایی را رمز میکنند که مجدداً ویژگی پلیمراز را عوض میکنند و بنابراین پلیمراز، سری سوم ژنها را نیز رونویسی میکند. به این ترتیب، بیان ژنهای فاژ طی مراحل سازمان یافته صورت میگیرد که در آن، محصولات ژنهای زودرس، ژنهای دیگر را فعال میکنند.
- بیان ژن در آلودگی لیزوژنیک:
باکتریوفاژ λ به عنوان مدلی از بیان ژن در فاژ بسیار مورد مطالعه قرار گرفتهاست. در آلودگی E.coli با فاژ λ ممکن است یکی از دو مسیر لیتیک یا لیزوژنیک را دنبال کند. بیان ژن در لامبدا سه مرحله دارد: مرحله زودرس سریع، مرحله زودرس با تأخیر و مرحله دیررس. بیان ژنهای زودرس توسط دو راه انداز PL و PR تنظیم میشود که در دو سمت یک ژن تنظیمی به نام CI قرار دارند. ژن CI، یک پروتئین بازدارنده را رمز میکند. در طول مسیر لیزوژنی، رونویسی PL و PR به وسیله پروتئین CI مسدود میشود و هنگامیکه این پروتئین به PR منتقل میشود با راه انداز ci همپوشانی کرده و در این صورت بیان خود را نیز تحریک میکند. تا زمانیکه پروتئین CI حضور دارد، بیان ژنهای زودرس و دیررس مهار میشود و مرحله لیزوژنی ادامه پیدا میکند. انتخاب میان مسیرهای لیتیک و لیزوژنیک به عهده یکی از پروتئینهای لامبدا به نام CRO میباشد که به عنوان مهارکننده رونویسی ژن ci عمل میکند. پس از آلودگی، RNA پلی مراز میزبان، ژنهای λ را با تعدادی از راه اندازهای λ آغاز میکند که در نتیجه، ci بیان میشود و از رونویسی ژنهای زودرس جلوگیری میکند. پس مانع پیشرفت مسیر لیتیک میشود. ژن cro نیز بیان میشود و اگر تجمع پروتئین محصول ژن cro به حد کافی برسد، پروتئین CI مهار شده و در نتیجه مسیر لیتیک اجازه پیشرفت پیدا میکند و فعال میشود. به نظر میرسد که رقابت میان CRO و CI یا انتخاب میان مسیر لیتیک و لیزوژنیک فرایندی تصادفی باشد و به اینکه کدام پروتئین زودتر افزایش یابد بستگی دارد. تا زمانیکه CI به اندازه کافی موجود باشد سلول در حالت لیزوژنیک باقی میماند اما اگر سطح CI پایین بیاید، عمل لیز شدن (چرخه لیتیک) بهطور خودبه خود القاء خواهد شد. فعال شدن چرخه لیتیک توسط عواملی از جمله تابش پرتوهای یونیزان یا فرابنفش صورت میگیرد. این پرتوها یک مکانیسم حفاظتی عمومی در E.coli به نام پاسخ SOS را فعال میکنند. این مکانیسم شامل ژن RecA میباشد که پروتئین رمز شده آن، مهارکننده CI میباشد. این پروتئین، CI را تجزیه و غیر فعال میکند. وقتیکه CI به این روش غیر فعال شد ژنهای زودرس فعال میشوند. در این هنگام، مرحله لیزوژنیک به پایان رسیده و مسیر لیتیک آغاز میشود.
فاژ درمانی
در سال ۱۹۲۸، کشف پنی سیلین توسط الکساندر فلمینگ باعث شد تا فاژها فراموش شوند اما این فراموشی زیاد طول نکشید. استفاده وسیع از آنتی بیوتیکها و افزایش مقاومت به آن، پزشکان را مجبور کرد حتی برای عفونتهای معمولی نیز آخرین نسل آنتیبیوتیکها را تجویز کنند. این امر سبب شد تا توجه محققان دوباره به فاژ درمانی (به انگلیسی: phage therapy) جلب شود. فاژ درمانی جذابیتهای خود را دارد. برخلاف بیشتر آنتیبیوتیکها، فاژها اسلحههای هوشمندی هستند که اختصاصی عمل میکنند. فاژها در رشتههای دمی خود آنزیمی دارند که فقط با مولکولهای خاصی در سطح باکتریها واکنش میدهند. این آنزیمهای ویژه برای هرگونه از باکتریهای اختصاصی هستند. این بهآن مفهوم است که فاژها به باکتریهای مفید بدن مانند روده آسیب کمی وارد میکنند در حالی که آنتیبیوتیکها آنها را از بین میبرند.
همچنین فاژها خود محدودکننده هستند به نحوی که بعد از نابود کردن باکتریهای مضر، خود نیز از بین میروند. آنها به خصوص برای عفونتهای موضعی مانند عفونتهای استخوان یا زخمهای ناشی از دیابت مفید هستند. آنتیبیوتیکها نمیتوانند به این نواحی دسترسی پیدا کنند اما فاژها با تکثیر از طریق باکتریها میتوانند به نواحی عفونی عمقی نیز نفوذ کنند. به علاوه، تولید فاژها آسان و ارزان است، آلرژی را تحریک نمیکنند و اثرات جانبی کمی دارند.
پژوهشها در زمینه فاژ درمانی، بیشتر در کشورهای بلوک شرق به ویژه شوروی، گرجستان و لهستان انجام میپذیرفت اما با اتمام جنگ سرد، محققان در بسیاری از کشورهای اروپایی و امریکایی، به فاژ درمانی روی آوردهاند. از فاژ درمانی برای درمان عفونتهای ناشی از سودوموناس، استافیلوکوک اورئوس مقاوم به متی سیلین (به انگلیسی: MRSA)، استرپتوکوکها و اشریشیا کلی استفاده شدهاست.
منابع
- Mc Grath S and van Sinderen D (editors). (2007). Bacteriophage: Genetics and Molecular Biology (1st ed.). Caister Academic Press. ISBN 978-1-904455-14-1. [1].
- Mason, Kenneth A. , Jonathan B. Losos, Susan R. Singer, Peter H Raven, and George B. Johnson. (2011). Biology, p. 533. McGraw-Hill, New York. ISBN 978-0-07-893649-4.
